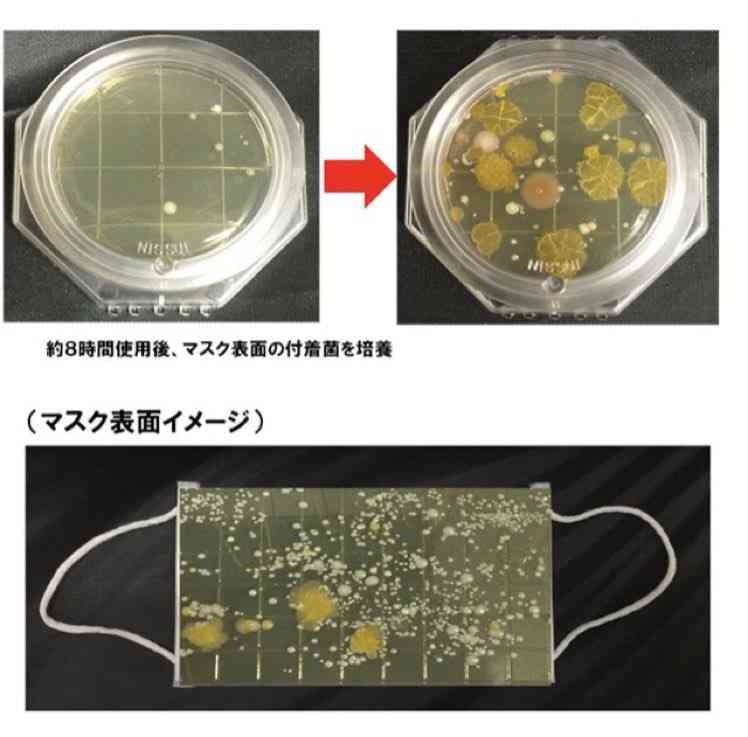

-
2452. 匿名 2022/05/11(水) 17:01:56
>>472
レストランのやカフェの店員さん、
コックさんはずっとしてて欲しいかも+7
-3
-
2464. 匿名 2022/05/11(水) 17:07:19
>>2452
マスクは黄色ブドウ球菌繁殖するから逆に不衛生です
必ず触ってしまうし、それで料理なんて本来ならNGですよ![]()
+8
-3
削除すべき不適切なコメントとして通報しますか?
いいえ
通報する
2452. 匿名 2022/05/11(水) 17:01:56
+7
-3
2464. 匿名 2022/05/11(水) 17:07:19
+8
-3
削除すべき不適切なコメントとして通報しますか?
いいえ
通報する